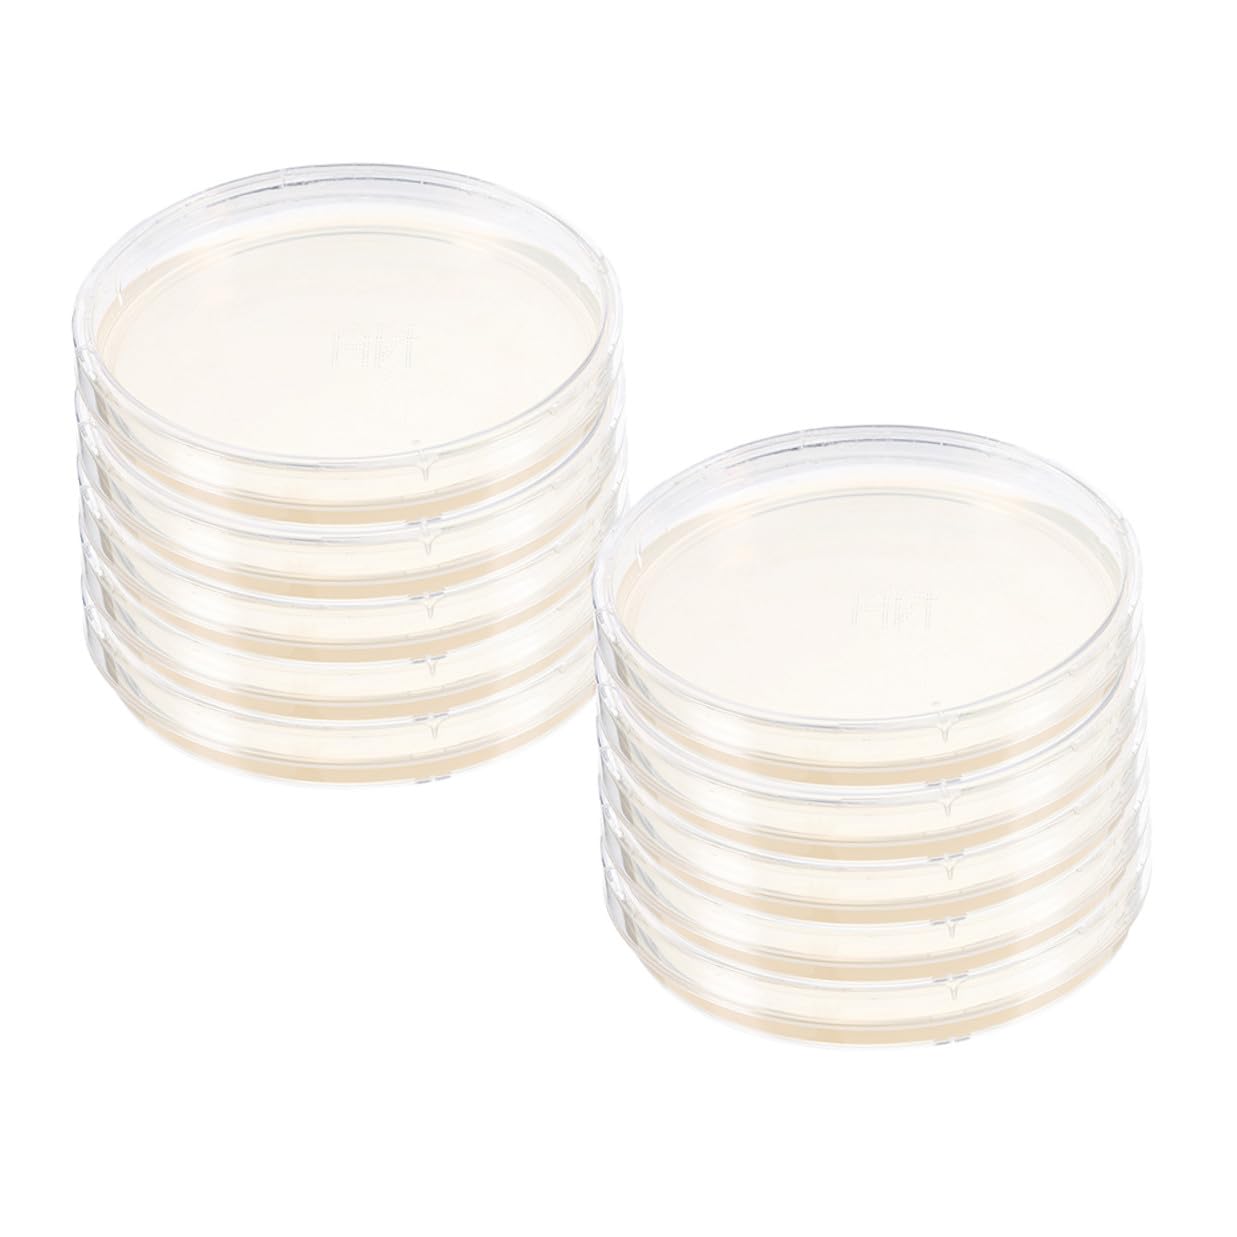
10pcs Nutrient Agar Plates 6cm Microbiology Petri Dishes Pre-Poured Agar for Laboratory Cell Specimen Storage

New
Arrivals/Restock
100 Packs Sterile Thick Plastic Petri Dishes with Lid, Vabiooth 90mm Dia x 15mm Deep Clear 3 Vents Petri Dish for Lab Science Experiment
 Limited Time Sale
Limited Time SaleUntil the end
13
54
12
US$28.79 cheaper than the new price!!
Free shipping for purchases over $99 ( Details )
Free cash-on-delivery fees for purchases over $99
Free cash-on-delivery fees for purchases over $99
See all stores
Please note that the sales price and tax displayed may differ between online and in-store. Also, the product may be out of stock in-store.
Used US$19.20
Product details
| Management number | 208365841 | Release Date | 2026/03/22 | List Price | US$19.20 | Model Number | 208365841 | ||
|---|---|---|---|---|---|---|---|---|---|
| Category | |||||||||
- Package: Sterile Plastic Petri Dishes: 100 Pack of 90mm diameter x 15mm deep Sterile Petri Dishes with Lids.【This is a plastic petri dish, please do not heat more than 120℉ or it will melt, if you need the Autoclavable dish, please click Autoclavable Model on our page】
- Sturdy & Thick: Ethylene oxide sterilization, The clear petri dish is made of high quality plastic material,solid and thick.Other brands on the market are only 12g, ours weighs 16g, Thicker and more durable
- 3 Vented Lids: Each petri plate has 3 lids so that there is improved air circulation and less condensation, Ideal for growing bacteria, mold, yeast, fungus and other organisms.
- Applicaiton: Laboratory analysis for medical,biological,scientific research and other activities.
- Warranty: If the product is damaged during transportation, please DM us, we will help you solve the issue.
| Manufacturer | Vabiooth |
|---|---|
| Item model number | VB-PD001-100 |
| Package Dimensions | 15.31 x 10.51 x 7.6 inches; 4.56 Pounds |
Correction of product information
If you notice any omissions or errors in the product information on this page, please use the correction request form below.
Correction Request Form